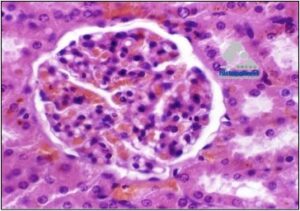

Autor:
Berrocal, A.
De forma breve explicaremos las diferentes tipos de técnicas o herramientas, que se utilizan en la patología moderna, con la intención de ayudar a obtener el objetivo final. Definimos dicho objetivo el determinar la causa o etiología de la enfermedad. Únicamente explicaremos con un poco mas de detalle el concepto de las TINCIONES ESPECIALES. Las otras técnicas solo las explicaremos brevemente.
A. El inmunodiagnóstico:
Es un técnica que detecta antígenos( inmunología) o reacciones químicas en los tejidos o células. Se puede hacer en material ya fijado (parafina), es la inmunohistoquímica. En el caso de preparaciones citológicas se llama inmunocitoquímica.

Uno de los grandes usos de esta técnica, es en la oncología diagnostica, ya que en cierto grupos de tumores indiferenciados, el conocer el origen celular de esa células neoplásicas. esto tiene mucho valor especialmente, si la neoplasia se va a tratar de forma no quirúrgica o como coadyuvante post-cirugía cirugía(drogas). Ejemplo, este es un rabdomiosarcoma cardiaco teñido con actina, vea que tiñen tanto las miofibrillas normales como las tumorales.

B. La microscopia electrónica:
Como se explico anteriormente, los marcadores de la inmunohistoquímica, son proteínas especificas, estructurales o secretadas por las células o los tejidos. En cambio en la microscopia electrónica, se trata de estructuras o componentes subcelulares como organelas, ejemplo mitocondrias o constituyentes extra celulares (matriz).
A pesar de su gran aporte para el entendimiento de las estructuras normales y alteradas, su uso, especialmente en el diagnostico diario, ha disminuido. Observe en la siguiente foto, las microvellosidades, mitocondrias, uniones celulares, etc.

C. Citometría de flujo:
Es una técnica de mucho valor, la cual permite estudiar a las células de forma individual, cuando ellas pasan por un rayo laser. Para las personas que quieran leer mas, hay mucha información (artículos), en internet.
D. El PCR para el reacomodo de los receptores de antígenos:
Es una técnica muy nueva, que se esta usando mucho en humanos. En medicina veterinaria, también se esta utilizando, especialmente en centros especializados de algunas universidades de los Estados Unidos( desconozco si también en otros países).
Es lo que se conoce como la clonación de células. Se utiliza, en neoplasia linfoides, en casos, en donde es muy difícil, incluso con inmunohistoquímica, saber si los linfocitos presentes, son en respuesta a una reacción inflamatoria, o si son neoplásicos, ya que los neoplásicos son homogéneos, por originarse de una única célula transformada.
E. Técnicas o tinciones especiales:
Muy probablemente es un concepto o término, con el que la mayoría de ustedes, están muy familiarizados, ya que con cierta frecuencia los llamo o les escribo, para informarles que a su caso necesitamos hacerle un tinción especial.
Son técnicas que se pueden utilizar de forma rutinaria, tanto en la citopatología, como en la histopatología. Este termino de “especial”, agrupa a tinciones realizadas por HISTOQUíMICA: Es un grupo de tinciones diferentes a la tinción estándar o rutinaria, conocida como Hematoxilina-Eosina(H&E) en el caso de la histopatología o el Giemsa o otros, en el caso de la citología. Dentro de sus principales ventajas de estas tinciones especiales están:
- La mayoría son relativamente rápidas( 3-4 días).
- Los protocolos son bastantes estándar y reproducibles.
- Son muy aceptadas, incluso artículos indizados( publicaciones).
- Son mas baratas que la inmunohistoquímica. Pero son menos especificas.
- La principal desventaja, es que a veces su reacción son poco predecibles.
SU USO. Se emplean para demostrar grupos específicos de químicos, o de algunas sustancias, por ejemplo mielina, glicógeno etc. También para visualizar la morfología de ciertos microorganismos, por ejemplo hongos, bacterias. ALGUNOS EJEMPLOS DE LAS MAS COMÚNMENTE UTILIZADAS
Para sustancias intra y extracelulares:
Sustancia extracelular. El Rojo Congo, se usa en casos de sospecha de amiloidosis.
Observe en las tres imágenes siguientes(glomérulos). La primera esta teñida con la tinción de rutina( Hematoxilina-Eosina). Las otras dos es con rojo Congo, observe como el material es un poco rojo( positivo).

Glomérulo, observe el material dentro del ovillo. H.E

Sustancia intra celular. Pared Intestinal. COLITIS HISTIOCÍTICA, especialmente, aunque no exclusiva de bóxers.







Para microorganismos:
Gram,
para distinguir entre bacterias Gram+ o Gram –


Giemsa, para protozoarios y algunas bacterias. También en citología diagnostica( Histopatovet). Vea los varios ejemplos de su uso:



Grocott (tinción de plata), especialmente Hongos, etc.


PAS, es para hongos. También, en sustancias intra-celulares.


Ziehl-Neelsen o FITE, especialmente para bacterias del grupo de las acido resistentes(Micobacterias). En la primera, los macrófagos, tienen mucho citoplasma espumoso. En el FITE se ven como “bananitos”.


Comentario final:
Algunas de estas tinciones especiales, las hace el laboratorio con el que HISTOPATOVET trabaja. Otras tinciones, al igual que algunas inmunohistoquímicas, las enviamos a un centro de diagnostico especializado en Michigan, Estados Unidos.

